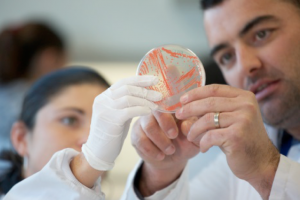
Capture d’écran 2016-03-30 à 22.21.48

DEINOVE
DEINOVE is an industrial biotechnology company based in Montpellier that develops processes for producing various compounds by biotechnological means.
Its historical project is the development of a process for
producing second generation biofuels. DEINOVE relies for this on a new bacterial genus,
Deinococcus, very little studied and exploited compared to the chassis conventionally used in the industry:
Escherichia coliand
Saccharomyces cerevisiae.
Owing to its thermophilic properties and its metabolic capacities, Deinococcus might turn out to be a new industrial hotel relevant to industry. DEINOVE then developed a first-rank metabolic – genetic (synthetic biology) and fermentation – engineering platform.
DEINOVE has collected about
6 000 strains of this genus or of a related genus, and the second part of its activity developed more recenty consists in exploiting the biodiversity of its strain library for
specialty applications: producing high value-added compounds such as carotenoids, proteins, lipids, etc. which form part of the composition of cosmetic products, nutraceuticals, or food additives for animal nutrition. DEINOVE works
together with partners to industrialize its processes: biomass producers, biofuel producers, chemistry groups, manufacturers of application markets, etc. The Company is in particular engaged in research collaborations with two French partners: Avril to develop a process for producing natural additives for animal feed; Suez Environnement for recovering urban waste that is then recycled into biofuel. It has also signed agreements with two Americans, including Flint Hills Resources in animal feed. DEINOVE has to date filed more than
170 international patent applications. The Company has nearly 50 collaborators on 1500 m2 of in-house laboratories.
Created in 2006, the Company is firmly heading towards a pre-industrial pilot stage.